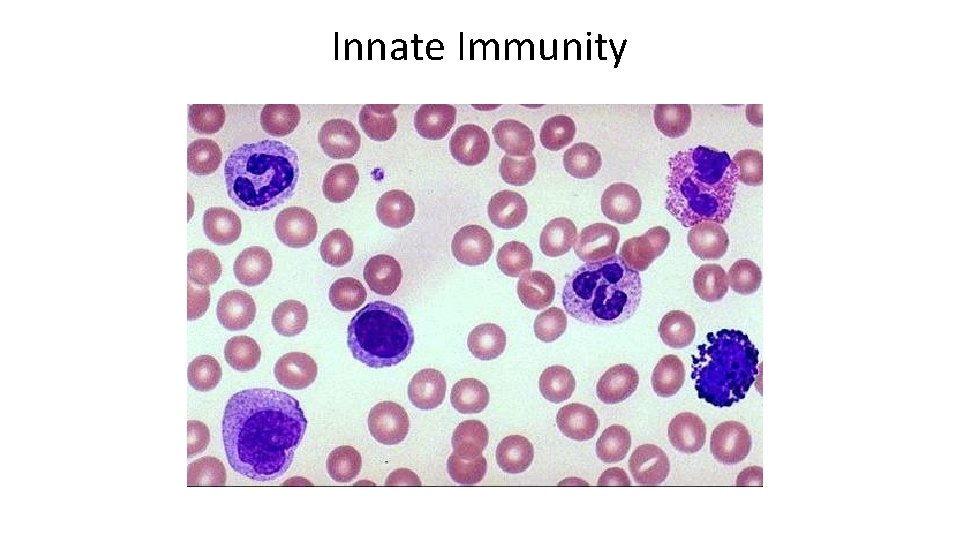
Innate Immunity

Immune System Dr Anderson Rowan University Immune System










































































- Slides: 74

Immune System Dr. Anderson Rowan University

Immune System • Function: To protect the body from infection and disease. This is based on the body’s ability to distinguish SELF from NONSELF.

Immune Branches • Innate – immune function present at birth • Acquired (Adaptive) – immune function that develops over time from exposure to pathogens in the environment – Like what?
Innate Immunity

Innate Immunity • Barriers to pathogens that are inherent at birth, they do not require previous exposure to pathogens – Integument (skin) – White blood cells

Integument • Establishes a physical barrier between vulnerable cells and infectious agents

Skin Defenses • Physical Barriers – Dead dry skin cells – Dendritic cells – modified monocytes -phagocytose invading microorganisms • Chemical Barriers – High salt concentration – Antimicrobial peptides (AMPs), e. g. defensins – Lysozyme – lyses bacterial cell membranes

Mucus Membranes • Line all openings of the body (respiratory, digestive, urinary and reproductive) • Consist of epithelial cells with a basement layer of connective tissue (collagen)

Epithelial Defense • Shedding of cells carries away pathogens that may try to invade the body • Chemical Agents – – Mucus (physical barrier) that contains lysozyme and AMPs to destroy bacterial cell walls

Second Line of Defense • If primary (integument) barrier is breached, pathogens must be eliminated • Pathogens “reveal” themselves to the immune system via PAMPs (Pathogen-Associated Molecular Patterns) • Depending on the PAMP, specific immune responses will be initiated

Leukocytes • Specifically engage different invaders of the body (pathogen types) • Divided into granulocytes and agranulocytes due to their appearance under the microscope – Granulocytes – many stained organelles giving them a “grainy” appearance – Agranulocytes – few or no organelles

Specific Jobs of Leukocytes Granulocytes • Basophils – produce histamine leading to inflammatory response • Neutrophils – phagocytose bacteria and viruses • Eosinophils – lead attack against parasitic worms

Specific Jobs of Leukocytes Lymphocytes • Lymphocytes – produce antibodies against specific invaders – B lymphocytes – produce antibodies to pathogens – T lymphocytes • produce cytokines that direct immune response • Destroy infected cells • These cells the heart of adaptive immunity, as they will “remember” the antibodies they produced, and be able to make them again quickly upon reexposure to a pathogen (memory cells)

Specific Jobs of Leukocytes - Monocytes • Monocytes – function to phagocytose bacteria and other invading pathogens • Will mature into macrophages which can leave the blood vessels and enter tissues (diapedesis) where pathogens frequently enter

Differential Hemocyte Count • Depending on the pathogen, infection will cause changes in the proportion of WBC’s in the blood

Differential WBC Count 8000 7000 6000 5000 4000 Normal Infected 3000 2000 1000 yt es oc on M Ly m ph o cy te s hi ls so p Ba op sin Eo Ne ut ro ph ils hi ls 0

Phagocytosis • WBC’s (Macrophages, eosinophils and neutrophils) surround and engulf pathogens • WBC then adheres to the pathogen via binding of cell membrane components – This process can be facilitated by opsonization- antibodies or other proteins mark the pathogen for death

Phagocytosis • Once adherence is complete, pathogens are engulfed via endocytosis, which forms a phagosome • The contents of the phagosome are then digested by merging with a lysosome (vesicle in the cell containing digestive enzymes)


Toxin Secretion • Cells such as eosinophils and lymphocytes can kill cells by secreting toxic compounds directly on to them • Enzymes in the cell membrane of these cells can form reactive oxygen species (ROS) such as hydrogen peroxide to kill nearby cells

Non- Specific Chemical Defenses of Blood • Interferons – Protein molecules released by host cells to inhibit virus spread • Infected cells produce interferon which causes neighboring cells to produce antiviral proteins • Anti-viral proteins inhibit viral m. RNA synthesis and protein translation at ribosomes

Complement • Proteins in the blood plasma that bind to pathogens and mark them for destruction (opsonization) • After pathogen detection, a complex molecular pathway results in complement products that – Facilitates Chemotaxis – recruits WBC’s to the pathogen – Produces membrane attack complex (MAC) which bores a hole in the pathogen’s cell membrane, killing the cell

Inflammation • Acute Inflammation – quick, short-lived response to infection, usually beneficial • Chronic Inflammation – Long lasting, generally damaging reaction to infection which itself can cause disease • Signs include: Reddened skin, localized heat, edema and pain

Inflammation (Acute) • Dilates blood vessels and makes them more permeable – Delivers more blood and resources to the site of infection – This results in rapid healing • Recruits phagocytes – To kill infectious pathogens and prevent the spread of infection

Fever • Presence of certain PAMPs (pyrogens) results in another chemical cascade that triggers the hypothalamus to increase the normal temperature of the body • Fever increases the efficiency of complement and decreases pathogen replication rates resulting in faster recovery from infection

Temperature • All organisms function optimally within a relatively narrow temperature range 22 C 37 C 30 C


Acquired Immunity

Acquired Immunity • Acquired immunity is built up over time and after exposure to certain pathogens • Acquired immunity is largely through the production of antibodies which recognize antigens on germs – Example?

Antigens • Substances on cell surfaces or produced by cells that can provoke an immune response e. g. PAMPs (non-self!) – Lipopolysaccharide (LPS) e. g. - bacteria – Peptidoglycan (PG) e. g. – bacteria – Beta 1, 3, Glucans (fungi) – ANY OTHER foreign proteins that the immune system can mount a response to (non-self)

Complete Antigens • Can stimulate the proliferation of lymphocytes and antibodies (immunogenicity) • React to activated lymphocytes and antibodies produced by the immune response (reactivity) • Examples?

Antigenic Determinants (Epitopes) • The immunogenic part of an antigen • This is where antibodies or leucocyte receptors bind to attack • Large proteins can have many antigenic determinants – why?

Haptens • Very small molecules that are foreign to the body, but not immunogenic • However, a combination of a hapten and a “self” protein can mount an immune response – Have reactivity, but not immunogenicity • Usually results in a harmful immune response

What’s the Hapten?

Lymphocytes – Acquired Immunity • B- Lymphocytes – Primarily produce antibodies against a very specific species of pathogen • T-lymphocytes – Cytotoxic “killer” cells – destroy infected body cells (CD 8) – Helper cells (CD 4) • How do lymphocytes know what to kill?

Major Histocompatibility Complex (MHC) • The protein matrix on your cells that displays either “self” proteins” or “non-self” proteins

MHC – Normal vs. Infected Cells • Uninfected cells display a small protein derived from normal cell processes (metabolism) – Correct password! • Infected cells display protein, but parts of the foreign (pathogen) antigen are attached – Incorrect password (and consequences)

MHC Classes • Body cells – Possess MHC I complex that will “display” either: – “Self” Proteins – Healthy cells – Antigens (parts of pathogens) – Sick cell • Immune Cells (Lymphocytes, antigen presenting cells, etc. ) will display – “Self” Proteins – Healthy cells – Antigens (parts of pathogens) – To activate other immune cells

MHC in Lymphocytes

Antigen-Presenting Cells • Cells that present antigen fragments to T-cells (in thymus) for maturation – Dendritic cells (in connective tissue) – Macrophages – B-lymphocytes • These cells engulf pathogens and then present portions of their antigens to T-cells

Dendritic Migration • After phagocytizing a pathogen, dendritic cells will move to the lymph vessels where they express antigens on their surface • T-cells encounter these presented antigens and start their specific immune response • Dendritic cells are the bridge between innate and adaptive immunity!!!

Humoral (Plasma-based) Immune Response • Starts when a B-cell (lymphocyte) encounters a pathogen antigen • Antigen-receptor complex is brought into the cell • This stimulates the cell to “clone” itself via mitosis, thus making more cells that are competent against the pathogen that started the cascade

B-Cell Proliferation

Plasma Cells • Most cloned B-lymphocytes become plasma cells – Secrete antibodies to the antigen (up to 2000 molecules/second) – Antibodies mark any cell with that antigen for destruction • Memory (B) cells are also produced – Exist for years to “prime” the immune system in case of reinfection

Memory Cells and Primary Immune Response • Primary Immune Response (1 st exposure) – Newly “presented” antigen causes Blymphocyte clones to proliferate over 3 -6 days • Secondary Immune Response – The now “primed” immune system can mount a much faster response when reexposed to the same pathogen – Cloned cells left over from primary response bind better to antigens, live longer

Active Humoral Immunity • Active – B-cells encounter antigens and make antibodies – Naturally acquired – How else? • Unfortunately, while providing lots of immediate protection, killed or weakened pathogens sometimes do not result in a strong cell-mediated (T H 1) response. • Immune memory suffers

Passive Humoral Immunity • Passive Immunity – Immune response is solely due to “artifical” antibodies • Horses, rabbits, bacteria, etc. – Protection ends when naturally degraded in the body • Maternal antibodies • Antivenom

Antibodies (Immunoglobulins) • Proteins secreted by effector B-cells – Bind specifically to ONE pathogen antigen, making them highly specific • Five classes of Ig (Immunoglobulins)

Antibody Classes • Ig. M – large antibody (pentamer) – released by plasma cells • Ig. A – monomer and/or dimer – mucus membranes • Ig. D – acts as B-cell receptor • Ig. G – most abundant, small, can cross placental barrier • Ig. E – involved in allergic reactions • See pg. 784 in the text for more details

Basic Antibody Structure Heavy Chain Light Chain Stem region = variable region

Antibody Structure • Heavy Chains(2) – identical structure, long chains (>400 aa long) • Light Chains (2) – much shorter than H chains, loop around heavy chains • Variable (V) regions – very different between individual antibodies • Constant (C) regions – very similar (almost identical) between antibodies in the same class

Basic Antibody Structure Antigen binding site Heavy Chain Light Chain Stem (Constant) region = variable region

Immune complexes • Antigen-antibody pairings – Result in • Neutralization – viral receptors or other virulence factors like toxins are bound and inactivated • Agglutination – Clumping of foreign cells – two or more pathogens bind to the same antibody • Precipitation – dissolved molecules (antigens) come out of solution • Complement fixation – bound antibodies attract complement that results in cell lysis

Antigen Receptor Diversity • Of all the pathogens and harmful foreign substances, how does your body recognize them all?

Antibody Diversity • Genetically coded • Much comes from hypervariable regions of the DNA in the cells that create them (B-Cells)

Somatic Recombination • Fairly few genes code the proteins that make up antigen receptors, but they are constantly “shuffled” • These combinations yield literally millions of different combinations of antigen receptor proteins

Cell-Mediated Immune Response • What happens if a pathogen avoids the antibody response? • T-cells (lymphocytes) are the primary cells that mediate the cellular response – CD 4 cells – CD 8 cells helper T cells cytotoxic T cells

Immunocompetent Cells (T - Lymphocytes) • React to antigens present on body cells (MHC I) – Must bind to foreign antigens – Must not react strongly to “self” antigens • Positive Selection – Only those cells that don’t recognize cell MHC (self) die via apoptosis • Negative Selection – Binding too tightly to self-antigens results in apoptosis (death)

Activating T-cells • In order to activate against a particular pathogen, a T-cell must recognize BOTH self and non-self (double recognition) – The antigen – The normal MHC of body cells

Body Cell Recognition (Review) • MHC (protein on cell membrane) displays a protein from cellular processes • If normal (recognized as self) the T-cell does not attack • If a bit of foreign antigen is presented in the MHC, the cell presenting it destroyed by the T-cell (endogenous antigen) – Examples?

Presentation is Half the Meal • The Class I MHC (most somatic cells) and what it displays are critically important in the cellular immune response, as it advertises infections hiding within the body cells • However, what about the class II MHC?

Class II MHC • Present on immune cells (dendritic cells, B-cells, macrophages) • Antigens displayed on Class II MHC come from antigens that have been engulfed by phagocytosis (exogenous antigen) – Examples?

(CD 4) T-Cell Activation

Specific T-cell Jobs (CD 8 – Cytotoxic Cells) • Directly attack and kill pathogens or compromised body cell (virus-infected or cancerous) – Recognize foreign invaders by antigens on MHC I – Once attached, cytotoxic cells release • Perforins – punch holes in the foreign cell membrane • Granzymes – enzymes that degrade the interior of the foreign cell, resulting in cell lysis via apoptosis

(CD 8) T-Cell Activation

Death of T-cells • After cloning and mobilization, T-cells die off in large numbers • This is thought to prevent injury to body cells in the long term

Regulatory T-Cells • Can dampen the immune response via cytokines (Interleukins) – Runaway immune responses can damage normal host cells as well as the infection or cancerous cells – What do we call this when it happens?

Overview of Cellular and Humoral Responses

Tissue Transplants and Immunity • MHC I may not be compatible between donor and receiver, initiating an immune response in the receiver – What can be done to help the patient accept the donated tissue? – What are the problems associated with doing this?

Extending Immunity into Diagnostics • FISH - (Fluorescent Immuno-sorbent Hybridization) • ELISA – (Enzyme-linked Immunosorbent Assay)



ELISA • ELISA is nothing more than a “molecular sandwich” • Pathogen added first • Rinse • Antibodies with linked enzymes added • Rinse • If pathogen was present, the enzymes on the antibody will cause a color change, indicating a positive sample

ELISA